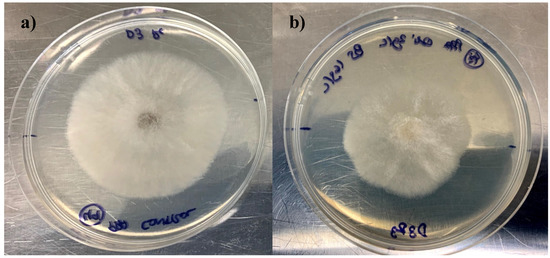

Abstract
Microbial contaminations represent an important issue for crop production, resulting in tons of losses worldwide every year. One of the highest-risk pathogens involved in these infections is Botrytis cinerea, which is responsible for the grey mold disease. In this study, a biosurfactant extracted from corn steep liquor (CSL), an agro-industrial residue from the corn-milling industry, was used in combination with copper oxychloride (Cu-Oxy), a copper-based pesticide, to evaluate their fungitoxic activity on B. cinerea cells. The results showed that the mixture of 2 g/L of Cu-Oxy with 16 g/L of the biosurfactant extract from CSL, named biosurfactant pesticide formulation (BS-P), helped in the reduction of colony growth, in the decrease of biomass production, and in the improvement of copper bioaccumulation on fungal mycelium in comparison with aqueous solutions of commercial and pure-copper-based fungicides. A factorial design was conducted to obtain the best operational conditions for enhancing the bioaccumulation of copper by B. cinerea cells in the presence of BS-P, resulting in a maximum copper uptake of 2122 µg Cu/g dry weight when using 1 g/L of Cu-Oxy combined with 8 g/L of CSL biosurfactant extract at an incubation temperature of 15 °C. It was also proved that, due to the absence of the biosurfactant extract, the amount of copper bio-adsorbed by fungal mycelium was considerably decreased and, therefore, so was its fungitoxic activity. These results suggest that the biosurfactant extract studied could be involved in eco-friendlier pesticide formulations, reducing the environmental impact of copper-based active principles.
1. Introduction
B. cinerea is commonly known for being responsible for the grey mold disease, and it is considered to be an important fungus phytopathogen that can infect around two hundred plant species, causing elevated economic losses in crops around the world [1]. It has been classified among the top ten fungal plant pathogens, occupying the second place in the ranking only after the Magnaporthe oryzae [2,3]. The costs of damages caused by B. cinerea are very difficult to estimate because they affect all the different stages of the supply chain, from crop cultivation to storage, transport, or market distribution, with wine and table grapes being one of the more affected sectors [4]. In this sense, it is important to highlight that the B. cinerea fungus has developed a tolerance to most specific botrycides, including benzimidazoles, phenylcarbamates, sulphamides, and other commercial fungicides [5,6]. Therefore, developing new and more effective antimicrobials against high-risk pathogens such as B. cinerea is needed. In recent studies, the potential of copper nanoparticles (Cu-NPs) was tested either alone [7] or in combination with conventional fungicides [8] against the fungus B. cinerea. Moreover, a higher fungitoxic effect of Cu-NPs against some fungal plant pathogens in comparison with commercial copper-based fungicides, such as copper (II) hydroxide or copper sulphate, was also proved [9].
In addition, the promising future of biosurfactants in agrochemical applications can be highlighted [10], removing plant pathogens due to its antimicrobial activity [11]. In fact, the effectiveness of lipopeptides as biopesticides against the fungus B. cinerea has already been tested [12], as well as the role of rhamnolipids against the plant pathogen Phytophthora sojae [13] and also against Fusarium verticillioides, the main pathogen of maize cultivars [14]. Another application of biosurfactants in agrochemical industry is focused on replacing the chemical surfactants available in commercial fungicide formulations [15] in order to obtain eco-friendlier and more effective fungicides. In fact, it was found that a biosurfactant obtained from Pseudomonas sp. B0406 was able to significantly increase the aqueous solubility of two hydrophobic pesticides (methyl parathion and endosulfan) and, consequently, their fungicide effectiveness [16]. However, the high cost of production of biosurfactants represents a challenge that prevents these metabolites from being used in industrial applications. Currently, the capacity of a biosurfactant extract obtained from corn steep liquor (CSL) was also tested in order to increase the aqueous solubility of both copper oxychloride (Cu-Oxy) and cuprous oxide (Cu-Ox), two copper-based active principles that are widely used to control plant fungal diseases. It is important to highlight the exceptionally low water solubility of both Cu-Oxy and Cu-Ox (around 0.1% in both cases), which limits their fungicidal activity. However, this value was significantly increased to 96.5% for Cu-Oxy [17] and 13.2% for Cu-Ox [18] in the presence of the biosurfactant extract from CSL at concentrations of 16.1 g/L and 3.9 g/L, respectively. This biosurfactant extract obtained from CSL possesses the advantage that it is produced spontaneously in CSL [19], avoiding the cost of the fermentative process. Moreover, in a previous work [20], it was its antimicrobial activity was demonstrated on different pathogenic strains, such as Pseudomonas aeruginosa and Escherichia coli; however, its effect on microorganisms that infect crops such as B. cinerea has never been tested.
Considering the abovementioned, this work is focused on the evaluation of the fungitoxicity of a biosurfactant extract, with demonstrated antimicrobial capacity, alone or combined with Cu-Oxy on B. cinerea cells. Several parameters were studied, such as mycelial growth, biomass production, and percentage of inhibition of B. cinerea cultures, as well as the biosorption capacity of copper ions by the fungus cells. The effect of the Cu-Oxy concentration, biosurfactant concentration, and incubation temperature on the copper bioaccumulation in the mycelium was assessed by means of a Box–Behnken factorial design in order to establish theoretical predictions of copper bio-adsorption in the presence of the biosurfactant extract used and to provide the best fungitoxic conditions.
2. Materials and Methods
2.1. Extraction and Surface-Active Properties of a Biosurfactant Extract from Corn Steep Liquor
The extraction of the biosurfactant extract from CSL was carried out by performing a liquid–liquid (L-L) extraction with ethyl acetate as the organic solvent, following the protocol described by Vecino et al. [21]. Briefly, a mixture of CSL solution and ethyl acetate (1:3 v/v) was used for the extraction after 60 min of agitation at room temperature. Ethyl acetate was recovered after the extraction process by vacuum distillation, thus obtaining the biosurfactant extract. The CSL raw material was provided by Nutropam CSL (Companhia Portuguesa de Amidos, S.A. (COPAM), San João da Talha, Portugal), and ethyl acetate was supplied by CARLO ERBA Reagents, S.A.S (Val de Reuil Cedex, France).
Surface-active properties were measured by means of a Krüss K20 EasyDyne tensiometer with a platinum Willhemly plate of 1.9 cm (Krüss GmbH, Hamburg, Germany). All determinations were measured at room temperature by preparing triplicates of successive dilutions of a biosurfactant extract from CSL with an initial concentration of 1 g/L and graphing the concentration of each solution against the surface tension (ST) values in order to obtain the final value of critical micellar concentration (CMC) for the biosurfactant extract.
2.2. Preparation of Biosurfactant Pesticide Formulations
The pesticides used in this work to evaluate their fungitoxicity against B. cinerea cells were the pure Cu-Oxy (99.0% m/m) and the commercial fungicide (50% m/m of Cu-Oxy) at concentrations of 2 g/L in both cases. In addition, an eco-friendlier pesticide formulation including the combination of the pure Cu-Oxy with the biosurfactant extract obtained from CSL was also employed. This biosurfactant biopesticide formulation (BS-P) was prepared by mixing 2 g/L of pure Cu-Oxy with 16 g/L of the CSL biosurfactant extract. The BS-P was prepared by following the procedure described in a previous work [10] that consists of obtaining a homogeneous mixture in distilled water between the Cu-Oxy and the biosurfactant extract by stirring for 20 min in a shaker (150 rpm) at room temperature. The resulting aqueous solution containing the Cu-Oxy active principle partly dissolved was centrifuged for 10 min at 5000 rpm and filtered with a polytetrafluoroethylene (PTFE) membrane (0.45 μm) before being used for antimicrobial purposes. The pure reagent Cu-Oxy (99.0% m/m) was supplied by LGC Labor GmbH (Augsburg, Germany), and the commercial fungicide Cu-Oxy (50% m/m of Cu-Oxy) was provided by Solabiol (SBM Dévelopments SAS, Ecully, France). Both pure and commercial Cu-Oxy fungicides were employed in this work with the aim of comparing their fungitoxicity against B. cinerea cells.
2.3. Preliminary Experiments
2.3.1. Fungitoxic Effect of Biosurfactant Pesticides Formulations
The fungitoxic effect of different pesticide formulations was assessed against the fungal strain Botrytis cinerea Persoon 1794 (CECT-20973), which was obtained from the Spanish Type Culture Collection (CECT) (Valencia, Spain).
Working cultures of B. cinerea were prepared in sterilized Petri dishes with potato dextrose agar (PDA) medium, which was centrally inoculated with 30 µL of B. cinerea colonies containing 3 × 106 of colony forming units (CFU)/mL. These dishes were supplemented with 200 µL of each one of the pesticide formulations previously indicated in the previous section, Section 2.2 (pure Cu-Oxy 2 g/L, commercial Cu-Oxy 2 g/L and the BS-P), in order to evaluate their influence in the development of fungal colonies and, consequently, their fungitoxicity. A Petri dish with only inoculated B. cinerea cells was used as a control test. Then, all dishes were incubated at 26 °C for 5 days, and the following parameters were daily measured: dry mycelium biomass, radial growth, and percentage of growth inhibition. The dry mycelium biomass was obtained by removing the B. cinerea cells from the dishes, washed twice with Milli-Q ultrapure water, and dried at 80 °C for 48 h to achieve a constant weight, following the methodology carried out by Gharieb [6]. The radial growth, expressed in mm, of the developed colonies was measured by drawing two cardinal diameters in the bottom of the dish. The percentage of growth inhibition was calculated in reference to the control test. This methodology was performed following previous publications [22,23].
2.3.2. Bioaccumulation of Copper on the Botrytis Cinerea Mycelium
To assess the amount of copper that was bio-adsorbed by B. cinerea mycelium, the different worked cell cultures were incubated for 5 days at 26 °C. After this, the developed cells were removed from the Petri dishes, washed twice with Milli-Q ultrapure water, and dried at 80 °C for 48 h, until reaching a constant weight. Then, the dry-weight mycelium (between 0.5 and 6 mg) was treated with both 1 mL of hyper-pure nitric acid (69% m/m) and 1 mL of hydrogen peroxide (30% m/v) during 1 h at 90 °C to complete the dissolution of the solid sample. Each digestion solution was transferred to a 5 mL volumetric flask and completed to the final volume with Milli-Q ultrapure water. Finally, the copper concentration in these solutions was quantified in order to evaluate its uptake by fungal cells. This methodology was carried out by following the protocol established by Gharieb (2002) [24]. All the experiments were performed in triplicates. The reagents employed for acid dissolution were supplied by Panreac (nitric acid) and Carlo Erba (hydrogen peroxide) and all of them were of a high-quality analytical reagent grade.
The copper content in the dissolved samples was measured by a Perking Elmer Atomic Absorption Spectrophotometer, model AAnalyst 800, equipped with a Zeemam background correction and THGA tubes. The furnace program used involves an ash temperature of 1200 °C and an atomization temperature of 2000 °C, observing linearity in the range of 0.20–20 µg/L. Detection and quantification limits were calculated as the concentration corresponding to three or ten times the standard deviation of the background noise, and the values found were 0.20 and 0.67 µg/L, respectively. This methodology was performed by following previous publications [24,25].
2.4. Factorial Design for Improving Copper Bioaccumulation by Botrytis Cinerea Cells in Presence of Biosurfactant Pesticide Formulations
The synergic effect of a CSL biosurfactant extract in the fungitoxicity of Cu-Oxy against B. cinerea cells was evaluated by quantifying the amount of copper bioaccumulated by the fungal mycelium. For this purpose, an incomplete Box–Behnken factorial design [26] was employed to obtain the specific relationship between the optimized variables and the bio-adsorbed copper ions.
The independent variables optimized were the concentration of Cu-Oxy, coded as x1; the concentration of CSL biosurfactant extract, coded as x2; and the incubation temperature, coded as x3. The dependent variable, coded as y1, was the bioaccumulation of copper on the B. cinerea mycelium. The limits established for the independent variables ranged from 0 to 2 g/L for x1 (Cu-Oxy concentration), 0 to 16 g/L for x2 (biosurfactant extract concentration), and 4 to 26 °C for x3 (incubation time). The ranges established for the independent variables x1 and x2 were chosen by taking into account the results obtained in a previous work regarding the solubility of pure Cu-Oxy in the presence of CSL biosurfactant extracts [10]. In addition, the range of the variable x3 was established by considering the most favorable incubation temperatures for the growth of B. cinerea cells. Coded values of −1 (minimum limit), 0 (central point), and +1 (maximum limit) were assigned for all independent variables and represent the ranges of the operational conditions established for each variable accordingly (Table 1).

Table 1.
Independent and dependent variables used in this study. (BS—biosurfactant.)
The 15 experiments corresponding to the matrix of the Box–Behnken factorial design are presented in Table 2. These experiments were developed by incubating working cultures of B. cinerea for 5 days and following the experimental procedure that was described above, in Section 2.3.2, but using the range of the independent variables (x1, x2, and x3) defined in Table 1. It is important to note that all the experiments were conducted in duplicates and that the sequence of the 15 experiments was performed randomly; thus, the possibility of systematic errors was reduced. The experimental results were analyzed by means of the response surface method with the Design-Expert Version 13 software (Stat-Ease, Inc., Minneapolis, MN, USA) by fitting the experimental data to a quadratic equation, Equation (1), where y represents the dependent variable, β indicates the regression coefficients calculated by multiple regressions using the least squares method, and x denotes the independent variables.
y = β0 + β1x1 + β2x2 + β3x3 + β12x1x2 + β13x1x3 + β23x2x3 + β11x12 + β22x22 + β33x32

Table 2.
Operational conditions used in this study, expressed as coded independent dimensionless variables, namely concentration of Cu-Oxy (x1), concentration of the CSL biosurfactant extract (x2), and incubation temperature (x3); and the results obtained for the dependent variable, bioaccumulation of copper (y1).
This equation is used to predict the copper bioaccumulated in B. cinerea cells in the presence of the CSL biosurfactant extract, thus providing the best fungitoxic conditions against the high-risk plant pathogen studied.
3. Results and Discussion
3.1. Fungitoxicity of Copper Oxychloride in Presence of a Corn Steep Liquor Biosurfactant
Preliminary experiments were carried out to evaluate the influence of a biosurfactant extract obtained from CSL on the fungitoxicity of the active principle of Cu-Oxy against the B. cinerea pathogen. The biosurfactant employed was able to reduce the ST of water up to 40 mN/m with a CMC of 440.4 mg/L, which agrees with the values obtained in a previous work, where the ST reduction was in the range of 36.9–38.0 mN/m, and the CMC was from 424.1 to 442.1 mg/L for biosurfactant extracts obtained from CSL [18]. Figure 1 shows the progress of the measured parameters, such as the radial growth, the inhibition percentage of colony formation, and the dry weight of biomass in working colonies of B. cinerea incubated for five days at 26 °C. The fungicides evaluated were commercial pesticide Cu-Oxy (2 g/L), pure Cu-Oxy (2 g/L), and a BS-P formed by a mixture of pure Cu-Oxy (2 g/L) and CSL biosurfactant extract (16 g/L). In Figure 1a, the radial growth (expressed in mm) of all the colonies studied is shown, and the values of this parameter were clearly inferior when the cultures were supplemented with the BS-P. This is the best combination to reduce the growth of the studied strain during incubation periods ranging from 2 to 4 days. In addition, in Figure 2, the pictures of two B. cinerea cultures after 3 incubation days at 26 °C can be observed, corresponding to the control test (Figure 2a) and a culture inoculated with the BS-P (Figure 2b). In these images, the significant reduction of the colony diameter in the presence of the BS-P can be highlighted, which is in consonance with the minor growth of radial diameter observed in Figure 1a between days 2 and 4 of incubation. In fact, on the third day of incubation, the radius of both the control test and the biopesticide’s presence was 29.67 and 24.33 mm, respectively. The same effect was also observed for the percentage of inhibition of colony formation that was calculated in respect to the control test (Figure 1b), particularly in the first four days of incubation. Thus, on the third day, the higher percentage of inhibition (19.23%) corresponds to the B. cinerea culture supplemented with the BS-P. Furthermore, the amount of dry biomass (expressed in mg) can be observed in Figure 1c, and a good agreement with the above results was found when the presence of the BS-P provided lower biomass values after the third day of incubation. Nevertheless, the most significant differences in the biomass were found on the fifth day of incubation, where the biomass value obtained in the presence of the BS-P (2.45 mg) was even less than half of that obtained in the control test (5.50 mg), representing a reduction percentage of 55.4% in the biomass production in the presence of the BS-P, thus obtaining better results than with the commercial pesticide (23.6%) or the pure Cu-Oxy (around 0%). Other authors [27] also proved the high antifungal activity of eco-friendly nanomaterials based on silica, chitosan, and Cu-nanoparticles (NPs) and their combination against B. cinerea. The in vitro assays showed that the highest reduction of colony growth was achieved when using both the silica-NPs and the silica–chitosan–Cu-NPS (43% in both cases) compared to a percentage of inhibition of only 25% in the presence of Cu-NPs at concentrations of 4 mg/mL in all cases. The in vivo assays that were developed at the end of the cold storage also confirm that the use of the silica-NPs and the silica–chitosan–Cu-NPS, applied at 3 g/L allowed for a reduction in the percentage of rotted fruit between 54 and 56%; these are values considerably higher than those achieve with Cu-NPs (8%).

Figure 1.
(a) Radial growth (mm), (b) percentage of inhibition (%), and (c) dry weight biomass (mg) of B. cinerea cultures supplemented with different pesticide formulations (2 g/L of pure Cu-Oxy, 2 g/L of commercial Cu-Oxy, and a BS-P) and a control test after 5 days of incubation at 26 °C.
Figure 2.
Pictures of Botrytis cinerea cultures after 3 days of incubation at 26 °C, corresponding to the control test (a) and supplemented with a BS-P (b).
In addition, the influence of a biosurfactant extract from CSL in the bioaccumulation of copper by B. cinerea cells was also evaluated after 5 days of incubation at 26 °C. The results, which are expressed in µg Cu/g dry mycelium, are shown in Figure 3. As it can be observed in Figure 3, the copper bioaccumulated by the fungal pathogen was significantly increased when using the BS-P, i.e., Cu-Oxy in the presence of the biosurfactant extract from CSL. Thus, the working culture supplemented with the BS-P allowed for the bioaccumulation of 607.2 µg Cu/g dry weight, and this value was considerably higher than those obtained when using the same principle active in the absence of the extract. In fact, the copper uptake obtained when using both commercial Cu-Oxy fungicide (2 g/L) and pure Cu-Oxy (2 g/L) was only 15.2 and 12.7 µg Cu/g dry weight, respectively. The statistical comparison of these results by means of Tukey’s b-test also corroborates the significant differences (p values < 0.05) between the copper bioaccumulated when using the BS-P culture medium regarding other growing media assayed. Furthermore, it was also proved in previous work [17] that the presence of CSL biosurfactant extract significantly increased the water solubility of the Cu-Oxy fungicide, which could enhance the copper uptake by the B. cinerea mycelium, thus decreasing its spore spreading and, consequently, its radial growth and dry-weight biomass, as can be observed in the graphics of Figure 1a,c, respectively. In summary, these results suggest that BS-P is the most fungitoxic formulation against the B. cinerea resistant fungus, with the additional advantage of being an eco-friendlier formulation compared to conventional ones, because it does not contain other chemical additives in its composition.

Figure 3.
Bioaccumulation of copper in B. cinerea cells, expressed as µg Cu/g dry weight, in a control test and in working cultures inoculated with different pesticide formulations (2 g/L of commercial Cu-Oxy, 2 g/L of pure Cu-Oxy, and a BS-P) after 5 days of incubation at 26 °C. Different Latin letters indicate significant differences among culture medium (Tukey’s b-test; p < 0.05).
Other authors [16] also proved that a biosurfactant obtained from Pseudomonas sp. B0406 was able to enhance the water solubility of two hydrophobic pesticides (methyl parathion and endosulfan), increasing their solubility from 0.41 at 0.92 mg/L for endosulfan and from 34.58 at 48.10 mg/L for methyl parathion, therefore improving the availability of these pesticides towards microorganisms and, thus, their fungicide effectiveness. In a previous work [24], it was reported that a significant correlation between the solubilization of the Cu-Oxy fungicide and the bioaccumulation of copper by Aspergillus niger mycelium was found. In fact, the addition of calcium to the fungicide significantly enhanced the solubility of the active principle and doubled the cellular copper content (from 0.08 to 0.16 µmol/mg dry weight) after 2 h of incubation. In addition, the dry weight of the fungal mycelium growth after 5 days of incubation also revealed an important increase of the fungicidal toxicity in the presence of calcium.
Recently, the potential of different nanoparticles (NPs) against some plant pathogens, including B. cinerea, was also tested, and it was observed that Cu-NPs were more fungitoxic than other conventional copper-based fungicides, such as copper (II) hydroxide or even copper sulphate, in most of the fungi evaluated. In the case of B. cinerea, the percentage of inhibition of colony formation achieved with Cu-NPs (70.58%) was considerably higher than that obtained with the reference fungicide copper (II) hydroxide (44.11%) at the same fungicide dose (1000 µg/mL) [8]. The same effect on antifungal activity was also found by Cu-NPs at a concentration of 100 µg /L, achieving a significant percentage of inhibition against B. cinerea (94.12%) and Sclerotinia sclerotiorum (92.48%), whereas CuSO4 inhibited the growth of these pathogens by only 58.82 and 77.44%, respectively, at a 40-times-higher concentration (4000 µg/mL). Nevertheless, these results are more favorable than those obtained with a recommended chemical fungicide (Topsin-M 70 WP) at a dose of 1000 µg/mL, where the growth inhibition was only 9.8% against B. cinerea and 75.56% against S. sclerotiorum [28]. In addition, the effect of combining Cu-NPs and other conventional fungicides (thiophanate methyl and fluazinam) was also evaluated, to which B. cinerea has developed resistance. In this sense, the synergic activity developed both in vitro and in vivo experiments carried out with different phenotypes of B. cinerea inoculated with a mixture formed by Cu-NPs and fluazinam must be highlighted. Important increments in the percentage of inhibition of colony formation were observed when using the combination Cu-NPs and fluazinam (40–43%) compared with the low values of mycelium suppression achieved by both Cu-NPs (8–28%) and fluazinam (9–22%) employed separately [9].
3.2. Factorial Design for Improving Copper Bioaccumulation by Botrytis Cinerea Cells in Presence of Biosurfactant Pesticide Formulations
The bioaccumulation of copper (y1) by B. cinerea cells that were inoculated with different pesticide formulations was evaluated under different concentrations of Cu-Oxy (x1), different concentrations of the biosurfactant extract from CSL (x2), and different incubation temperatures (x3), conducting a Box–Behnken factorial design of 15 experiments [26]. The experimental results obtained for the dependent variable, bioaccumulation of copper (y1), can be observed in Table 2, as well as the operational conditions of each experiment, described by means of the independent variables (x1−x3). All of these results are expressed as the mean value of two determinations.
Regression coefficients were calculated with experiments 1 to 12, whereas the experiments 13 to 15 represent the central point of the studied system, which was designed to estimate the possible influence of the experimental errors. Table 3 shows the regression coefficients and their statistical significance, expressed as p-values, for the bioaccumulation of Cu (y1) by B. cinerea cells. Those coefficients with p-values lower than 0.05 were considered to be statistically significant. In regard to these results, the experiments conducted showed that the concentration of Cu-Oxy (x1) and the concentration of the biosurfactant extract from CSL (x2) were the most influential variables on the copper bio-adsorption. In addition, the interaction of both variables was also significant, as well as their quadratic coefficients. In contrast, for the incubation temperature (x3), only the quadratic term was found to be significant. This means that the bioaccumulation of copper by B. cinerea fungus is positively influenced by the presence of the CSL biosurfactant extract, thus highlighting its antimicrobial activity against plant pathogens. These results are in good agreement with those obtained in a previous work [10], where it was demonstrated that lipopeptides produced by Bacillus XT1 CECT 8661 produced in controlled fermentation inhibited the growth of B. cinerea colonies by reducing the mycelium diameter from 19 to 71% when using concentrations of lipopeptides from 2 to 10 mg/L after 15 days of incubation at 25 °C.

Table 3.
Regression coefficients and their statistical significance for the dependent variable y1 (bioaccumulation of copper).
By replacing the significant regression coefficients shown in Table 3, in Equation (1), and mentioned in the factorial design section from the Material and Methods, a theoretical equation, Equation (2), was obtained. This equation allows us to predict the amount of copper bioaccumulated (y1) by B. cinerea cells as follows:
where x1, x2, and x3 are the concentration of Cu-Oxy in g/L, the concentration of the biosurfactant extract from CSL in g/L, and the temperature of incubation in °C, respectively.
y1 = 2122 + 334.07x1 + 303.75x2 + 310.93x1x2 − 849.42x12 − 907.62x22 − 912.94x32
To evaluate the suitability of the factorial design in regard to the experimental results, the r2 value obtained was 0.995, which corroborates that the theoretical model can predict with accuracy the cellular copper accumulated (y1) by B. cinerea mycelium within the ranges of variation defined for each independent variable in Table 1.
Moreover, Figure 4 shows the 3D response surface plots regarding the variation of the bioaccumulation of copper (y1) with the concentration of Cu-Oxy (x1) and the concentration of the biosurfactant extract from CSL (x2) at different temperatures of incubation (x3): (a) 4 °C, (b) 15 °C, and (c) 26 °C.

Figure 4.
Three-dimensional response surface plots showing the variation of the dependent variable, showing the bioaccumulation of copper (y1) with the concentration of Cu-Oxy (x1)−[Cu-Oxy] and the concentration of CSL biosurfactant (x2)—[BS] when using different temperatures of incubation (x3): (a) 4 °C, (b) 15 °C, and (c) 26 °C.
Figure 4 shows an increase in the copper uptake by B. cinerea fungus when increasing the incubation temperature from 4 to 15 °C, with the bioaccumulation of Cu being reduced at 26 °C—though this was higher than at 4 °C. In general, it was observed that the uptake of copper was significantly increased when using the active principle of Cu-Oxy in the presence of the biosurfactant extract from CSL, showing its capacity as an enhancer of fungitoxicity.
It can be observed in Figure 4b that the highest amount of copper bioaccumulated in the fungal strain, with a value of 2122 µg Cu/g dry weight, was achieved when using the experimental conditions corresponding to the central point of the factorial design, with this being an optimum value regarding the copper bio-adsorption. Therefore, a higher Cu-Oxy permeation was observed at intermediate temperatures of 15 °C rather than at the optimal temperature of B. cinerea. Usually, microorganisms acquire different phenotypes depending on the fermentation conditions and probably, at 15 °C, B. cinerea acquires a more permeable structure to Cu-Oxy, favored also by the presence of the biosurfactant extract. These results complement those obtained by López-Prieto et al. [17], who proved that the CSL biosurfactant extract is able to dissolve up to 96.5% of copper in aqueous solutions, hence showing its capacity to be a carrier of copper in biopesticide formulations facilitating its intake by plant pathogens such as B. cinerea. In addition, the results of this work are in good agreement with those reported in previous research, where the increasing solubility of Cu-Oxy was correlated with the improvement of copper bioaccumulated by A. niger mycelium; however, in this case, the variable that increased the solubility and bioaccumulation of copper was the presence of calcium [24]. In this sense, in a previous work [29] it was also proved that the combined formulation of insoluble copper compounds (copper hydroxide (CuHyOx), Cu-Oxy, and tribasic copper sulphate (CuTBS)), along with synthetic hydroxyapatite (HA), significantly enhanced the release and absorption of Cu (II) ions by B. cinerea cells regarding in vitro assays made in the absence of HA. A significant increase in the percentage of growth inhibition was observed when using HA concentrations of 6%, especially for CuHyOx and Cu-Oxy at all copper concentrations assayed (0.05, 0.1, and 0.2%), being more notable at the highest copper dose (0.2%). However, it is important to remark that this formulation does not include natural compounds comparable with the biosurfactant extract under evaluation. The literature about the use of biosurfactant extracts for improving the permeation of agrochemical active principles is almost inexistent.
Finally, the theoretical equation reported by the factorial design allowed us to estimate the experimental conditions to use the minimum quantity of Cu-Oxy, within the ranges established in Table 1, to maximize the bioaccumulation of copper in B. cinerea cells and, consequently, its fungitoxicity. In this sense, Equation (2) predicts that with only 0.51 g/L of Cu-Oxy and 8.67 g/L of the CSL biosurfactant extract at an incubation temperature of 15 °C, it is possible to accumulate 1766 µg Cu/g dry weight, a value considerably higher than that obtained when using the same concentration of Cu-Oxy and incubation temperature in the absence of the biosurfactant extract (695 µg Cu/g dry weight). These results highlight the role of the CSL biosurfactant extract as an enhancer of the solubility of copper-based pesticides and carrier of these active principles to be more easily bio-adsorbed and bioaccumulated by fungal mycelia in eco-friendlier pesticide formulations.
4. Conclusions
The results obtained in this work allow us to conclude that the biosurfactant extract obtained from CSL increases Cu-Oxy permeation through B. cinerea plant pathogen cells. The combination of Cu-Oxy with the biosurfactant extract was able to significantly inhibit the growth of B. cinerea colonies with lower mycelium diameters and lower biomass production under favorable microbial growth conditions when comparing with the control test. The biosurfactant extract under evaluation improved, to a high extent, the permeation of Cu-Oxy in comparison to commercial Cu-Oxy pesticide without the biosurfactant extract. The formulation recommended for achieving the maximum Cu-Oxy permeation values through B. cinerea cells at intermediate temperatures consists of 1 g/L of Cu-Oxy and 8 g/L of the biosurfactant extract.
Moreover, in this work, it was demonstrated that it is possible to establish theoretical equations that allow us to calculate permeation values for Cu-Oxy under different scenarios of temperature (4–26 °C), Cu-Oxy concentrations (up to 2 g/L), and biosurfactant concentrations (up to 16 g/L).
Taking into consideration the scarce literature available about the use of biosurfactants in agrochemical formulations, this work opens the door for testing the effect of biosurfactant extracts on the permeation of active principles, with the aim of improving their performance and reducing the minimum inhibitory dose when added to crops. It must be considered that the current work was carried out under very favorable conditions for the growth of B. cinerea; hence, in a real scenario, the effect of the biosurfactant extract could be even more favorable, and this will be considered in future works.
Author Contributions
A.L.-P. and B.P.-C. conducted all the experimental work and the treatment of the data and also participated in the writing of the paper; A.B.M. collaborated on the design of the experiments, the treatment of the data, and the writing of the paper; J.M.C. collaborated on the design of the experiments and the treatment of the data. All authors have read and agreed to the published version of the manuscript.
Funding
This research received no external funding.
Institutional Review Board Statement
Not applicable.
Informed Consent Statement
Not applicable.
Data Availability Statement
The datasets used and/or analyzed during the current study are available from the corresponding author upon reasonable request.
Acknowledgments
The authors thank to the Spanish Ministry of Science and Innovation (MICINN) for the financial support of this research under the projects RTI2018-093610-B-100 and PDC2022-133432-100.
Conflicts of Interest
The authors declare no conflict of interest.
References
- Li, X.; Yang, J.; Jiang, Q.; Tang, L.; Xue, Z.; Wang, H.; Zhao, D.; Miao, J.; Liu, X. Baseline sensitivity and control efficacy of a new QiI fungicide, florylpicoxamid, against Botrytis cinerea. Pest Manag. Sci. 2022, 78, 5184–5190. [Google Scholar] [CrossRef] [PubMed]
- Dean, R.; Van Kan, J.A.L.; Pretorius, Z.A.; Hammond-Kosack, K.E.; Di Pietro, A.; Spanu, P.D.; Rudd, J.J.; Dickman, M.; Kahmann, R.; Ellis, J.; et al. The Top 10 fungal pathogens in molecular plant pathology. Mol. Plant Pathol. 2012, 13, 414–430. [Google Scholar] [CrossRef] [PubMed]
- Nix, J. 10 Plant Diseases to Watch out for in 2022. 2022, Biome Makers Blog. Available online: https://biomemakers.com/blog/plant-diseases-to-watch-out-for-in-2022 (accessed on 10 April 2023).
- Steiger, D. Global economic importance of Botrytis protection. In Proceedings of the Book of Abstracts, 14th International Botrytis Symposium, Cape Town, South Africa, 21–26 October 2007; Fourie, P., Vivier, M., Eds.; AFRICAN SUN MeDIA Pty (Ltd.): Cape Town, South Africa, 2007. [Google Scholar]
- FRAC. List of Confirmed Cases of Plant Pathogenic Organisms Resistant to Disease Control Agents. 2020. Available online: https://www.frac.info/docs/default-source/publications/list-of-resistant-plant-pathogens/list-of-first-confirmed-cases-of-plant-pathogenic-organisms-resistant-to-disease-control-agents_05_2020.pdf?sfvrsn=7073499a_2 (accessed on 20 January 2023).
- Leroch, M.; Kretschmer, M.; Hahn, M. Fungicide resistance phenotypes of Botrytis cinerea isolates from commercial vineyards in South West Germany. J. Phytopathol. 2011, 159, 63–65. [Google Scholar] [CrossRef]
- Kovačec, E.; Regvar, M.; van Elteren, J.T.; Arcon, I.; Papp, T.; Makovec, D.; Vogel-Mikuš, K. Biotransformation of copper oxide nanoparticles by the pathogenic fungus Botrytis cinerea. Chemosphere 2017, 180, 178–185. [Google Scholar] [CrossRef] [PubMed]
- Malandrakis, A.A.; Kavroulakis, N.; Chrysikopoulos, C.V. Synergy between Cu-NPs and fungicides against Botrytis cinerea. Sci. Total Environ. 2020, 703, 135557. [Google Scholar] [CrossRef] [PubMed]
- Malandrakis, A.A.; Kavroulakis, N.; Chrysikopoulos, C.V. Use of copper, silver and zinc nanoparticles against foliar and soil-borne plant pathogens. Sci. Total Environ. 2019, 670, 292–299. [Google Scholar] [CrossRef]
- Naughton, P.J.; Marchant, R.; Naughton, V.; Banat, I.M. Microbial biosurfactants: Current trends and applications in agricultural and biomedical industries. J. Appl. Microbiol. 2019, 127, 12–28. [Google Scholar] [CrossRef]
- Sharma, D.; Kalita, S.; Duarah, K. Isolation and characterization of biosurfactant producing microorganisms and to determine its in vitro antagonistic activity against phytopathogenic fungi. Int. J. Curr. Trends Sci. Technol. 2017, 7, 20355–20367. [Google Scholar]
- Toral, L.; Rodríguez, M.; Béjar, V.; Sampedro, I. Antifungal activity of lipopeptides from Bacillus XT1 CECT 8661 against Botrytis cinerea. Front. Microbiol. 2018, 9, 1315. [Google Scholar] [CrossRef]
- Soltani Dashtbozor, S.; Miao, S.; Ju, L.K. Rhamnolipids as Environmentally Friendly Biopesticide Against Plant Pathogen Phytophthora sojae. Environ. Prog. Sustain. Energy 2016, 35, 169–173. [Google Scholar] [CrossRef]
- Borah, S.N.; Goswami, D.; Sarma, H.K.; Cameotra, S.S.; Deka, S. Rhamnolipid biosurfactant against Fusarium verticillioides to control stalk and ear rot disease of maize. Front. Microbiol. 2016, 7, 1505. [Google Scholar] [CrossRef] [PubMed]
- Roehrig, R.; Boller, W.; Forcelini, C.A.; Chechi, A. Use of surfactant with different volumes of fungicide application in soybean culture. Eng. Agrícola. 2018, 38, 577–589. [Google Scholar] [CrossRef]
- García-Reyes, S.; Yáñez-Ocampo, G.; Wong-Villarreal, A.; Rajaretinam, R.K.; Thavasimuthu, C.; Patiño, R.; Ortiz-Hernández, M.L. Partial characterization of a biosurfactant extracted from Pseudomonas sp. B0406 that enhances the solubility of pesticides. Environ. Technol. 2018, 39, 2622–2631. [Google Scholar] [CrossRef] [PubMed]
- López-Prieto, A.; Moldes, A.B.; Cruz, J.M.; Pérez Cid, B. Towards more Ecofriendly Pesticides: Use of Biosurfactants Obtained from the Corn Milling Industry as Solubilizing Agent of Copper Oxychloride. J. Surfactants Deterg. 2020, 23, 1055–1066. [Google Scholar] [CrossRef]
- López-Prieto, A.; Moldes, A.B.; Cruz, J.M.; Pérez Cid, B. Solubilization of cuprous oxide in water using biosurfactant extracts from corn steep liquor: A comparative study. Sci. Rep. 2022, 12, 2695. [Google Scholar] [CrossRef] [PubMed]
- López-Prieto, A.; Rodríguez-López, L.; Rincón-Fontán, M.; Cruz, J.M.; Moldes, A.B. Characterization of extracellular and cell bound biosurfactants produced by Aneurinibacillus aneurinilyticus isolated from commercial corn steep liquor. Microbiol. Res. 2021, 242, 126614. [Google Scholar] [CrossRef] [PubMed]
- López-Prieto, A.; Vecino, X.; Rodríguez-López, L.; Moldes, A.B.; Cruz, J.M. A multifunctional biosurfactant extract obtained from corn steep water as bactericide for agrifood industry. Foods 2019, 8, 410. [Google Scholar] [CrossRef]
- Vecino, X.; Barbosa-Pereira, L.; Devesa-Rey, R.; Cruz, J.M.; Moldes, A.B. Optimization of liquid–liquid extraction of biosurfactants from corn steep liquor. Bioprocess Biosyst. Eng. 2015, 38, 1629–1637. [Google Scholar] [CrossRef]
- Medina, A.; Magan, N. Comparisons of water activity and temperature impacts on growth of Fusarium langsethiae strains from northern Europe on oat-based media. Int. J. Food Microbiol. 2010, 142, 365–369. [Google Scholar] [CrossRef]
- Verheecke-Vaessen, C.; García-Cela, E.; López-Prieto, A.; Osk Jonsdottir, I.; Medina, A.; Magan, N. Water and temperature relations of Fusarium langsethiae strains and modelling of growth and T-2 and HT-2 mycotoxin production on oat-based matrices. Int. J. Food Microbiol. 2021, 348, 109203. [Google Scholar] [CrossRef]
- Gharieb, M.M. Biosorption and solubilization of copper oxychloride fungicide by Aspergillus niger and the influence of calcium. Biodegradation 2002, 13, 191–199. [Google Scholar] [CrossRef] [PubMed]
- Martins, F.; Soares, M.E.; Oliveira, I.; Pereira, J.A.; de Lourdes Bastos, M.; Baptista, P. Tolerance and bioaccumulation of copper by the entomopathogen Beauveria bassiana (bals.-criv.) vuill. exposed to various copper-based fungicides. Bull. Environ. Contam. Toxicol. 2012, 89, 53–60. [Google Scholar] [CrossRef] [PubMed]
- Box, G.E.; Hunter, J.S.; Hunter, W.G. Statistics for Experimenters: Design, Innovation and Discover, 2nd ed.; Wiley and Sons: Hoboken, NJ, USA, 2005. [Google Scholar]
- Hasim, A.F.; Youssef, K.; Abd-Elsalam, K.A. Ecofriendly nanomaterials for controlling gray mold of table grapes and maintaining postharvest quality. Eur. J. Plant Pathol. 2019, 154, 377–388. [Google Scholar] [CrossRef]
- Sadek, M.H.; Shabana, Y.M.; Sayed-Ahmed, K.; Abou Tabl, A.H. Antifungal activities of sulfur and copper nanoparticles against cucumber postharvest diseases caused by Botrytis cinerea and Sclerotinia sclerotiorum. J. Fungi 2022, 8, 412. [Google Scholar] [CrossRef]
- Battiston, E.; Antonielli, L.; Di Marco, S.; Fontaine, F.; Mugnai, L. Innovative delivery of Cu(II) ions by a nanostructured hydroxopatite: Potential application in planta to enhance the sustainable control of Plasmopara viticola. Phytopathology 2019, 109, 748–759. [Google Scholar] [CrossRef] [PubMed]
Disclaimer/Publisher’s Note: The statements, opinions and data contained in all publications are solely those of the individual author(s) and contributor(s) and not of MDPI and/or the editor(s). MDPI and/or the editor(s) disclaim responsibility for any injury to people or property resulting from any ideas, methods, instructions or products referred to in the content. |
© 2023 by the authors. Licensee MDPI, Basel, Switzerland. This article is an open access article distributed under the terms and conditions of the Creative Commons Attribution (CC BY) license (https://creativecommons.org/licenses/by/4.0/).